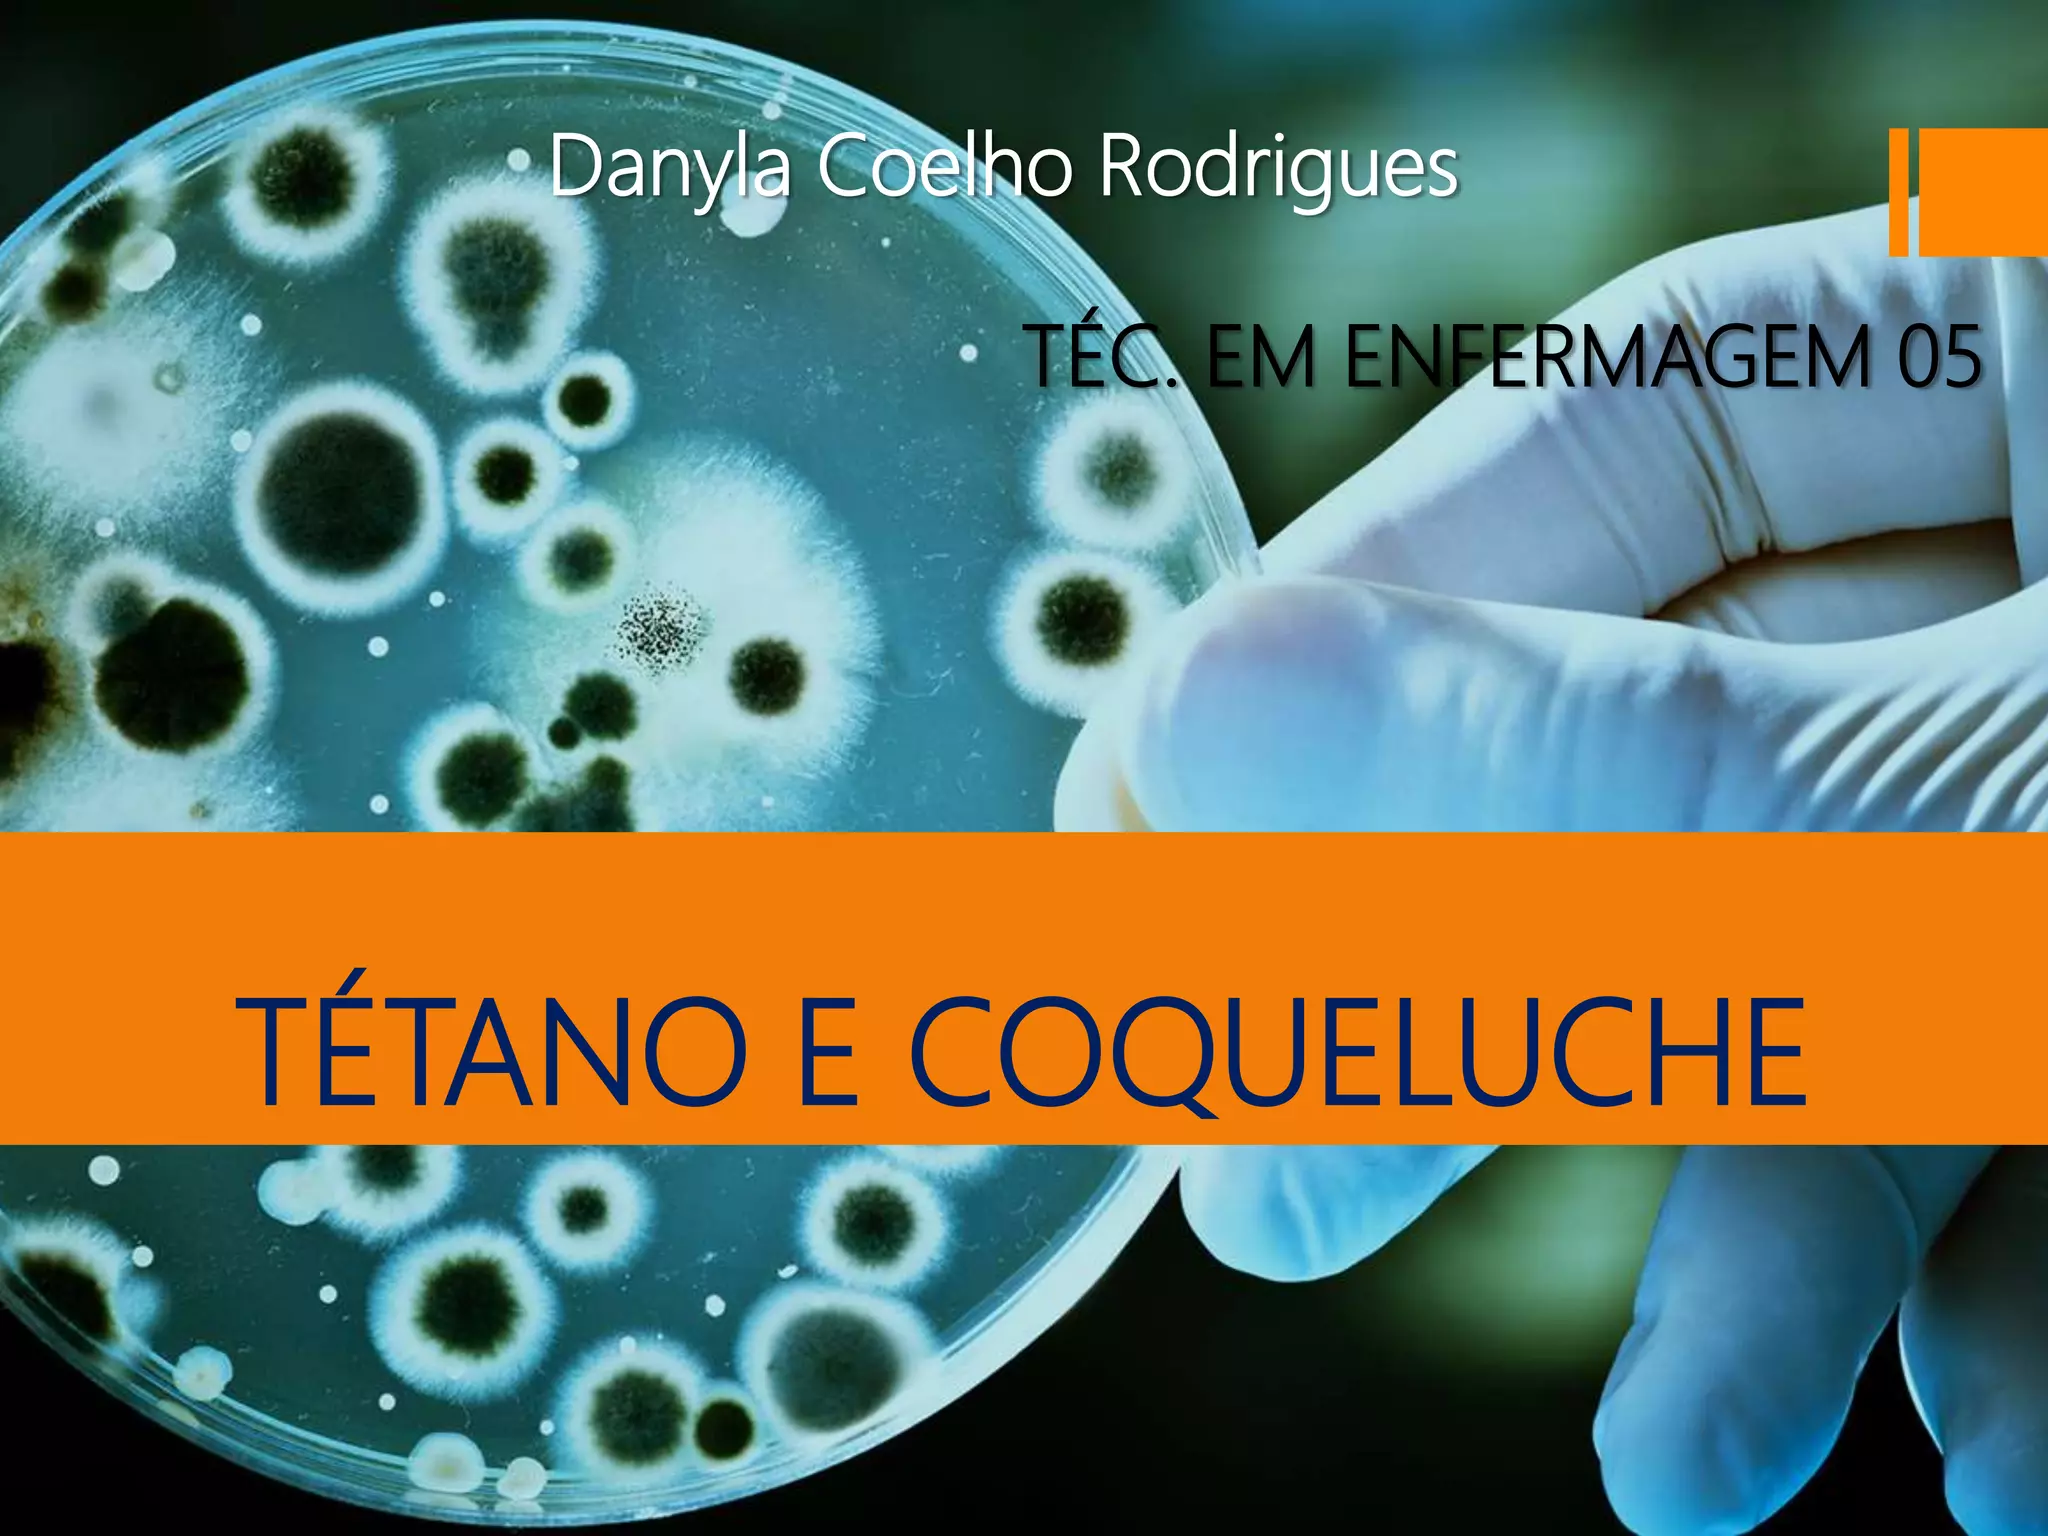

O documento descreve Tétano e Coqueluche, doenças bacterianas graves. O Tétano é causado pela bactéria Clostridium tetani e causa espasmos musculares dolorosos. A Coqueluche é causada pela bactéria Bordetella pertussis e causa tosse violenta e prolongada, podendo levar a complicações respiratórias. Ambas as doenças podem ser prevenidas com vacinação.